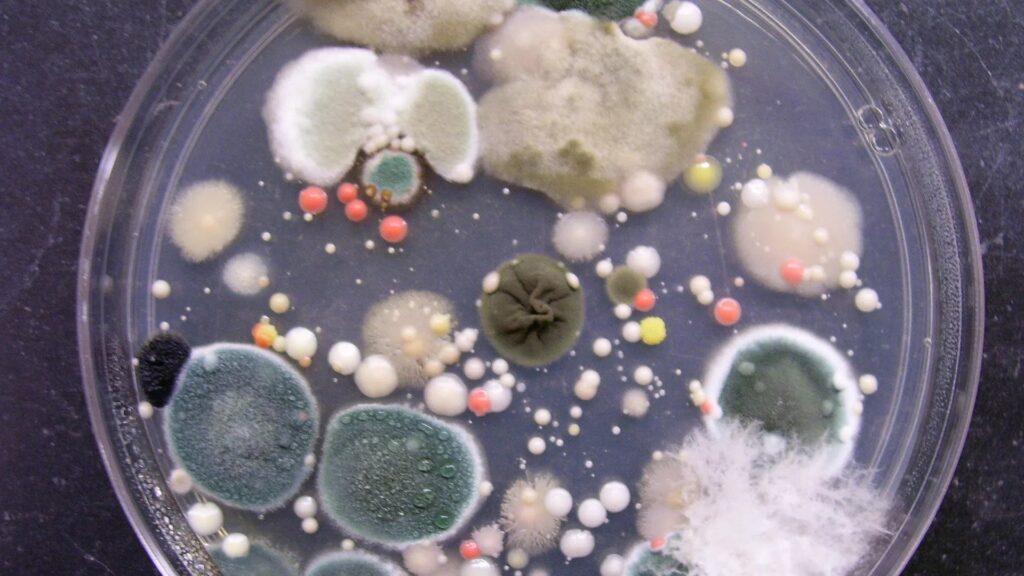

Shoes Dehumidifier, Shoes Deodorizer, Shoes Sterilizer, Shoes Dryer, Shoes Bacteria Killer, Shoes Bad Smell Remover, Shoes Sanitizer
Introduction to the Product
Introducing the Shoesterilizer Pro – the ultimate solution for keeping your footwear fresh, dry, and bacteria-free. Have you ever faced the discomfort of stinky shoes after a long day? Or wondered how to effectively eliminate moisture that can lead to unpleasant odors and harmful bacteria? The Shoes Dehumidifier and Sanitizer is here to solve those problems and revolutionize the way you care for your shoes.
With its cutting-edge technology, the Shoesterilizer Pro not only dries your shoes but also deodorizes, sterilizes, and eliminates harmful bacteria, ensuring a clean and comfortable wearing experience. Say goodbye to bad smells and hello to fresh, dry shoes!
What Sets It Apart
The Shoesterilizer Pro boasts a range of unique features that set it apart from typical shoe care products:
- Multi-Functionality: This device is not just a dryer; it deodorizes, sterilizes, and kills bacteria, making it a comprehensive shoe care solution.
- Advanced Technology: Utilizing UV-C light technology, this product effectively eliminates 99.9% of bacteria and viruses, ensuring your shoes remain hygienic.
- User-Friendly Design: Its sleek and compact design makes it easy to use and store, fitting into any shoe size while being lightweight enough to take on the go.
- Energy Efficient: The Shoesterilizer Pro is designed to operate quietly and efficiently, consuming minimal energy while delivering maximum performance.
User Experience
Users have reported an overwhelmingly positive experience with the Shoesterilizer Pro. The setup is straightforward – simply place the device in your shoes, turn it on, and let it work its magic.
Many users noted the following:
- Ease of Use: The intuitive controls make it easy for anyone to operate, regardless of tech-savviness.
- Effective Results: After a few cycles, shoes smell fresher, and users have noticed a significant reduction in moisture.
- Convenient Operation: The quiet operation allows users to run the machine during the night without disturbance.
Target Audience
The Shoesterilizer Pro is perfect for a variety of users:
- Athletes and Fitness Enthusiasts: For those who spend long hours working out, this product keeps athletic shoes fresh and dry.
- Professionals on the Go: Perfect for those who commute and want to ensure their work shoes are clean and odor-free.
- Families with Active Kids: Ideal for households with children who often come home with muddy shoes.
In-Depth Review
The Shoesterilizer Pro has received acclaim for its effectiveness in maintaining shoe hygiene. Users have highlighted its standout features, including:
- Deodorizing Power: Many have mentioned that the product not only removes odors but also leaves a pleasant scent behind.
- Drying Efficiency: Users report that shoes are thoroughly dried within a short period, making it a great option for rainy days.
- Bacterial Protection: The UV-C sterilization technology has provided peace of mind, knowing that their footwear is free from harmful microbes.
However, some users have noted that the initial investment may be higher than traditional methods, but the long-term benefits far outweigh the cost.
Pros and Cons
Pros:
- Multi-functional capabilities (dehumidifier, deodorizer, sterilizer)
- Effective UV-C technology for bacteria elimination
- User-friendly and compact design
- Energy-efficient operation
Cons:
- Higher initial cost compared to basic shoe care products
Explore Further
If you’re ready to say goodbye to bad-smelling shoes and hello to freshness, consider investing in the Shoesterilizer Pro today! For more information, user guides, and tips on maximizing your experience, visit our website or reach out to our support team.
Transform the way you care for your shoes and enjoy the comfort of knowing they are clean, dry, and ready for your next adventure!

There are no reviews yet.